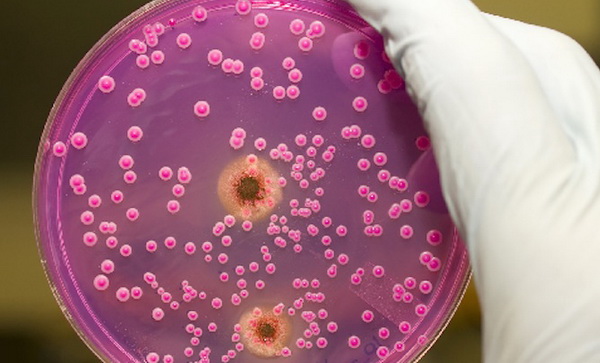
Анализы в лаборатории

Описание заболевания
Молочница возникает из-за патологического размножения грибка рода Кандида. Этот микроорганизм считается условно-патогенным, так как он постоянно присутствует в организме в небольших количествах. Однако при воздействии определенных факторов происходит его стремительное размножение, что приводит к диагностированию молочницы.
Данное заболевание трудно перепутать с другими, поскольку его симптомы ярко выражены и легко заметны. Женщина испытывает постоянный зуд и жжение в области половых органов. Также у нее наблюдаются выделения, имеющие творожистую неоднородную текстуру, белый цвет и резкий кисловатый запах. В дальнейшем может возникать боль во время полового акта.
Для терапии молочницы могут использоваться различные формы препаратов: таблетки, гели, мази, кремы и вагинальные суппозитории. Каждая из этих форм имеет свои преимущества и недостатки, поэтому выбор метода лечения должен осуществляться врачом с учетом нескольких факторов. Например, не все медикаменты подходят для беременных женщин. В таких случаях предпочтительно использовать средства с местным действием.
Заболевание может передаваться половым путем, поэтому лечение должно проходить одновременно для обоих партнеров.
Многие врачи утверждают, что однодневное лечение молочницы может быть неэффективным. Хотя существуют препараты, которые обещают быстрое облегчение симптомов, такие как противогрибковые таблетки или вагинальные свечи, полное излечение инфекции требует времени. Специалисты подчеркивают, что важно не только устранить симптомы, но и устранить причину заболевания. В некоторых случаях, если молочница вызвана нарушением микрофлоры или другими факторами, необходимо более длительное лечение и изменение образа жизни. Кроме того, самолечение может привести к рецидивам и осложнениям. Поэтому врачи рекомендуют обращаться за консультацией и следовать предписаниям, чтобы избежать повторного возникновения проблемы.

Медикаментозное лечение
Современная фармакология предлагает широкий ассортимент медикаментов для лечения молочницы у женщин. Многие из них обещают избавить от заболевания всего за один день. Однако стоит учитывать, что такие методы подходят лишь для легких форм кандидоза, так как с хроническими или запущенными случаями справиться гораздо сложнее.
Некоторые женщины пробуют на себе и затем рекомендуют другим новейшие способы быстрого избавления от молочницы. Например, существует мнение о том, что двойная доза Дифлюкана (две таблетки вместо одной) может помочь. Да, такое лечение может временно облегчить симптомы, но нет гарантии, что через месяц или два молочница не вернется, так как полноценного лечения не было проведено.
В то же время, многие препараты, назначаемые врачами, хоть и не способны вылечить молочницу за один день, быстро устраняют симптомы, что позволяет избежать дискомфорта. Полный курс лечения этими средствами эффективно справляется с молочницей, что снижает риск рецидива.
Наиболее часто назначаемыми препаратами для быстрого устранения молочницы являются:
- Пимафуцин, который доступен в различных формах. Врач обычно начинает с крема, а если он не дает результата, переходят к вагинальным суппозиториям и таблеткам.
- Крем Гиноформ. На сегодняшний день это один из лучших средств для борьбы с молочницей у женщин. Его активное вещество – бутоконазол.
- Полижинакс, который выпускается в форме вагинальных капсул и помогает не только при молочнице, но и при других бактериальных или вирусных инфекциях.
- Клотримазол, доступный в разных формах. Наиболее известен в виде крема, но также может использоваться в виде геля, мази и свечей.
- Препараты на основе кетоконазола, которые производятся в виде крема, таблеток и вагинальных суппозиториев. Это вещество эффективно при лечении острого кандидоза.
- Вагинальные суппозитории Клион-Д 100 быстро справляются с симптомами молочницы. В их составе два активных вещества – миконазол и метронидазол.
Курс лечения перечисленными препаратами при легкой форме молочницы может составлять от одного дня до недели. Поэтому, если сразу после появления первых симптомов обратиться к гинекологу, можно избавиться от молочницы всего за один день.
Для повышения эффективности лечения важно соблюдать все гигиенические рекомендации, связанные с данным заболеванием. Подмываться лучше не просто водой, а с использованием слабого раствора марганцовки или Фурацилина. Складки кожи в области паха следует промывать с антибактериальным мылом.
В это время лучше избегать использования различных гигиенических средств с отдушками. Также не стоит забывать о необходимости лечения полового партнера.
Важно помнить, что препараты для лечения молочницы за один день не подходят для беременных женщин и кормящих матерей. Им лучше использовать медикаменты, которые менее раздражают слизистую влагалища. Хотя это может занять больше времени, такой подход снизит стресс для организма матери.
| Аспект | Возможность победить молочницу за 1 день | Комментарии |
|---|---|---|
| Легкая форма (первичное проявление) | Маловероятно, но возможно значительное облегчение симптомов. | Применение сильных противогрибковых средств (например, однократная доза флуконазола или вагинальные свечи с высокими дозами клотримазола/нистатина) может быстро уменьшить зуд и жжение. Однако полное уничтожение грибка и предотвращение рецидивов за 24 часа крайне сложно. |
| Умеренная/тяжелая форма или рецидивирующая молочница | Практически невозможно. | В этих случаях требуется более длительное и комплексное лечение, включающее системные препараты, местные средства и, возможно, коррекцию сопутствующих факторов (например, иммунитета, питания). Однодневное лечение может дать лишь временное облегчение. |
| Профилактика рецидивов | Невозможно за 1 день. | Профилактика молочницы – это долгосрочный процесс, включающий изменение образа жизни, диеты, гигиены, а иногда и прием пробиотиков. Однодневные меры не могут обеспечить устойчивый эффект. |
| Диагностика | Невозможно за 1 день. | Для точной диагностики молочницы и исключения других инфекций может потребоваться мазок и лабораторное исследование, что занимает время. Самодиагностика и самолечение могут быть неэффективными и даже вредными. |
| Консультация с врачом | Рекомендуется в любом случае. | Только врач может правильно оценить ситуацию, назначить адекватное лечение и дать рекомендации по профилактике. Самолечение, особенно при рецидивирующей молочнице, может привести к хронизации процесса. |
Народные средства
Среди самых распространенных народных методов борьбы с молочницей можно выделить ванночки, спринцевание и подмывание отварами и настоями различных лекарственных трав. Эти способы эффективно помогают облегчить симптомы, но не всегда устраняют коренные причины заболевания.
Для быстрого лечения молочницы у женщин можно воспользоваться обычной солью, которая есть на каждой кухне. В один литр воды добавляют 2 столовые ложки соли, затем доводят до кипения и охлаждают до температуры около 40 градусов. После этого в раствор вводят столовую ложку соды, а затем фильтруют через марлю, чтобы убрать все ненужные частицы. В отфильтрованный раствор добавляют 5 капель йода. Полученным раствором рекомендуется спринцеваться дважды в день — утром и вечером.
Для подмывания интимной области можно использовать отвар ромашки или календулы. Для спринцевания подойдут настои шалфея, зверобоя, крапивы, череды или ромашки. Важно, чтобы температура средств для спринцевания или подмывания была комфортной для организма.
Отвар коры дуба также является эффективным средством, так как это растение обладает противовоспалительными, противозудными и антисептическими свойствами.
При легких формах молочницы применение народных средств может помочь избавиться от симптомов всего за один день. Тем не менее, всем женщинам следует помнить, что исчезновение зуда и жжения не означает полного излечения от болезни.
Молочница, или кандидоз, — это распространённое заболевание, которое вызывает множество вопросов у людей, страдающих от него. Многие интересуются, возможно ли избавиться от этой проблемы всего за один день. В интернете можно встретить разные мнения: некоторые утверждают, что с помощью аптечных препаратов и народных средств можно достичь быстрого результата, другие же предупреждают о необходимости комплексного подхода и времени для полного выздоровления. Врачи подчеркивают, что хотя симптомы могут утихнуть довольно быстро, полное устранение инфекции требует более длительного лечения. Кроме того, важно учитывать индивидуальные особенности организма и возможные причины возникновения молочницы. Поэтому, прежде чем принимать решение о лечении, стоит проконсультироваться со специалистом, чтобы избежать рецидивов и осложнений.

Системный подход к лечению
В большинстве случаев, когда возникает необходимость быстро избавиться от молочницы, врач назначает препараты с антимикотическим действием. Также могут быть рекомендованы антисептики, которые помогают очистить влагалище. Однако такие средства уничтожают не только вредные микроорганизмы, но и полезные.
Поэтому специалисты подчеркивают, что лечение молочницы должно быть комплексным.
Если после применения противогрибковых средств не восстановить нормальную микрофлору, это может привести к возникновению других заболеваний репродуктивной системы.
Таким образом, даже после устранения симптомов молочницы за один день женщине придется продолжать принимать препараты для восстановления микрофлоры в течение определенного времени.
Не стоит заниматься самолечением при молочнице, так как это может привести к неполному излечению. В результате могут образоваться так называемые ключевые клетки, содержащие патогенные или условно-патогенные микроорганизмы, которые временно находятся в неактивном состоянии. При стрессах, снижении иммунитета или в аналогичных ситуациях эти микроорганизмы могут активироваться и вызвать рецидив.
Лечение молочницы будет неэффективным, если не изменить привычный образ жизни. На время стоит отказаться от физических нагрузок, так как интенсивное потоотделение создает благоприятные условия для роста грибка.
Также важно пересмотреть свой рацион. Некоторые продукты могут вызывать жжение и зуд, это касается сладкого, острого, маринованного и пряного. Лучше отдавать предпочтение кашам, кисломолочным изделиям, овощам и фруктам.
Средства личной гигиены следует менять как можно чаще, минимум каждые 4 часа. Использование тампонов во время лечения не рекомендуется гинекологами.
Чтобы избежать необходимости срочного лечения молочницы, стоит уделить внимание профилактике. Заботиться о состоянии микрофлоры, регулярно посещать гинеколога и избегать сильных стрессов, которые могут ослабить иммунную систему, достаточно просто. Не все женщины знают, что в состав некоторых гигиенических средств входит молочная кислота, способствующая поддержанию нормального баланса микрофлоры.
Вопрос-ответ

Каковы основные симптомы молочницы?
Симптомы молочницы могут включать зуд и жжение в области влагалища, белые творожистые выделения, а также болезненные ощущения при мочеиспускании и половом акте. Если вы заметили эти симптомы, рекомендуется обратиться к врачу для подтверждения диагноза.
Какие методы лечения молочницы существуют?
Лечение молочницы может включать противогрибковые препараты, такие как кремы, таблетки или суппозитории. Важно следовать рекомендациям врача и завершить курс лечения, даже если симптомы исчезли раньше времени.
Можно ли предотвратить повторное возникновение молочницы?
Да, для предотвращения повторного возникновения молочницы рекомендуется соблюдать правила личной гигиены, избегать использования ароматизированных средств, носить хлопковое белье и поддерживать иммунную систему. Также стоит ограничить потребление сахара и углеводов, так как они могут способствовать росту грибков.
Советы
СОВЕТ №1
Обратитесь к врачу для получения точного диагноза. Молочница может иметь схожие симптомы с другими заболеваниями, поэтому важно убедиться, что именно она является причиной ваших проблем.
СОВЕТ №2
Используйте противогрибковые препараты, которые могут помочь в борьбе с молочницей. Некоторые из них доступны без рецепта, но лучше всего проконсультироваться с врачом перед началом лечения.
СОВЕТ №3
Соблюдайте гигиену и избегайте раздражающих факторов. Носите свободное, дышащее белье и избегайте использования ароматизированных средств личной гигиены, чтобы не усугубить состояние.
СОВЕТ №4
Поддерживайте иммунную систему. Правильное питание, достаточное количество сна и управление стрессом могут помочь вашему организму быстрее справиться с инфекцией.